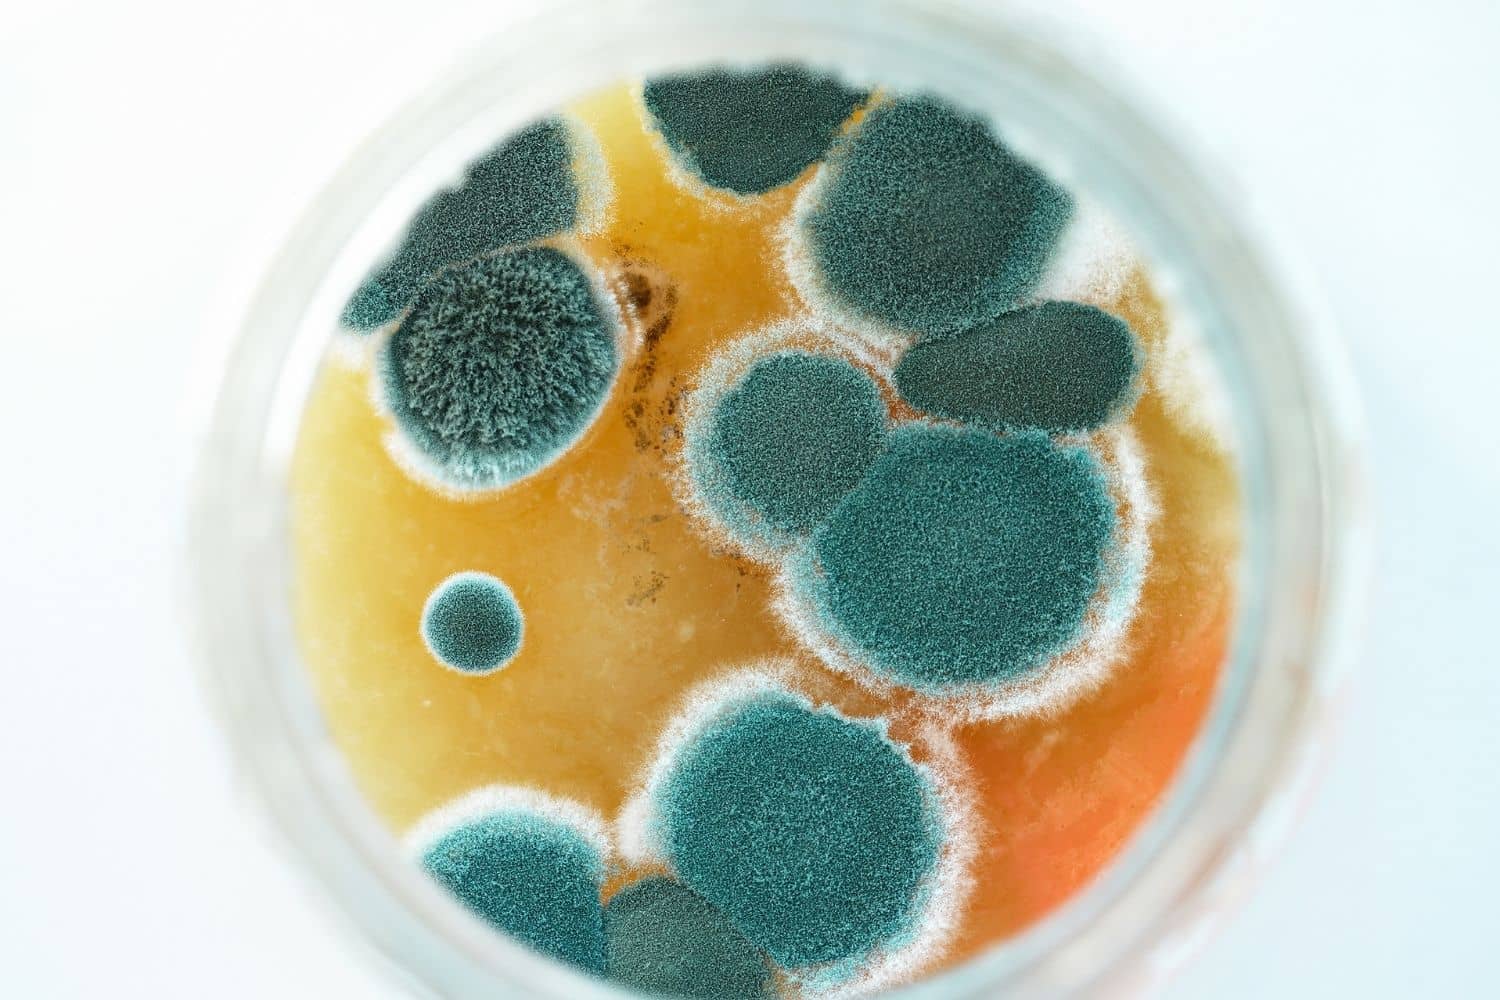
mold inspection

Mold Inspection Services in Columbia, MO
Detect Mold Early Before It Becomes A Problem
Molds are fungi that can be found both indoors and outdoors. They are a common source of indoor allergens and can cause a variety of health problems, including respiratory infections, asthma attacks, and other respiratory problems. If you suspect that you have a mold problem on your property, it is important to get it inspected by a professional as soon as possible.
ABC Environmental Contracting Services Of Columbia
offers mold inspection services that can help you identify the source of the problem and get it under control. We use state-of-the-art equipment to take samples of the indoor air and surfaces in your home, and our experienced inspectors will provide you with a report that includes their findings and recommendations.
Is There A Real Reason For Concern To Warrant A Mold Inspection?
Mold can cause high airborne spore exposures as well as a variety of health issues if it is present in your home. People who are exposed may develop allergies to the mold, as well as other health issues. If an allergy to the mold develops, common symptoms include coughing, sneezing, shortness of breath, and eye, nose, or throat irritation. Other health issues that are commonly experienced include brain fog, memory problems, fatigue, cramping, and numbness. In some cases, medical attention may be required. Mold contamination often remains undetected until health symptoms appear, so mold inspection is recommended to keep your loved ones healthy and safe.
Additionally, mold growth can damage your home’s carpet, walls, paintings, and more. If left untreated, mold growth can eventually cause expensive structural damage to your home.
We Work With Your Insurance Provider
At ABC Environmental Contracting Services Of Columbia, we understand the claims process and we will work with your insurance provider to make sure you get the coverage you deserve.
We understand that dealing with an insurance company can be a daunting task, but our team of experts will handle all the paperwork and correspondence for you. We'll also work with your insurance adjuster to make sure all the damages are properly documented and that you're getting the full coverage you're entitled to.
How We Approach Mold Inspections
The first step in our process is to send one of our certified mold inspectors to your home to perform a visual inspection. This inspection will help us determine the extent of the problem and identify any potential sources of mold growth.
Once the visual inspection is complete, we will take samples of the indoor air and surfaces in your home. These samples will be sent to a laboratory for analysis, and we will use the results of the lab tests to identify the type of mold that is present.
After the mold has been identified, we will develop a plan to get rid of it and prevent it from coming back. We will work with you to make sure that your home is back to normal as soon as possible.
With this comprehensive approach, you can be sure that your mold contamination will be taken care of quickly and efficiently. We are committed to providing the best possible service to our customers, and we will work with you every step of the way to make sure that your needs are met.
Mold is a serious problem, and spotting mold contamination before it grows out of control can save you thousands of dollars. This makes the cost of a mold inspection well worth a few hundred dollars when you are buying a new house.
Why Locals Prefer ABC Environmental Contracting Services Of Columbia In Mold Inspection Services
Our company specializes in mold inspection services, and we have the experience and expertise to safely and effectively remove all traces of mold from your home. ABC Environmental Contracting Services Of Columbia offers the following benefits:
- Ease of insurance claims
- Locally owned and operated
- Dependable emergency service
- Workmanship guarantee
- Expert knowledge and quality tools for detecting early mold
Our mold inspection specialists know all the telltale signs of mold growth, and they will carefully inspect your entire home in order to find every last trace of mold. Our techs use the best mold inspection equipment and innovative technologies so that you can be sure.
We Serve The Following Areas And Their Surrounding Communities
We are dedicated to providing our clients with the highest quality of service possible, and our team of certified professionals has the experience and knowledge necessary to handle any kind of restoration job. We offer comprehensive restoration services tailored to your situation. Whatever the case may be, our experts can assist you. Here are the areas we currently serve:
Get In Touch To Get A Free Estimate On Our Mold Inspection Services
Do you suspect that you may have a mold problem in your home? ABC Environmental Contracting Services Of Columbia offers comprehensive mold remediation and mold inspection services to identify the presence of mold and assess the extent of any damage. We also provide expert advice on how to remediate the problem and protect your property from future infestations.
Don't let a potential health hazard fester in your home - call us today for a free consultation! Our experienced professionals will take care of everything for you, from identifying the source of the problem to implementing a long-term solution. Contact us today to get started.
Mold Inspection FAQs
Get A Free Estimate
By filling out the form below